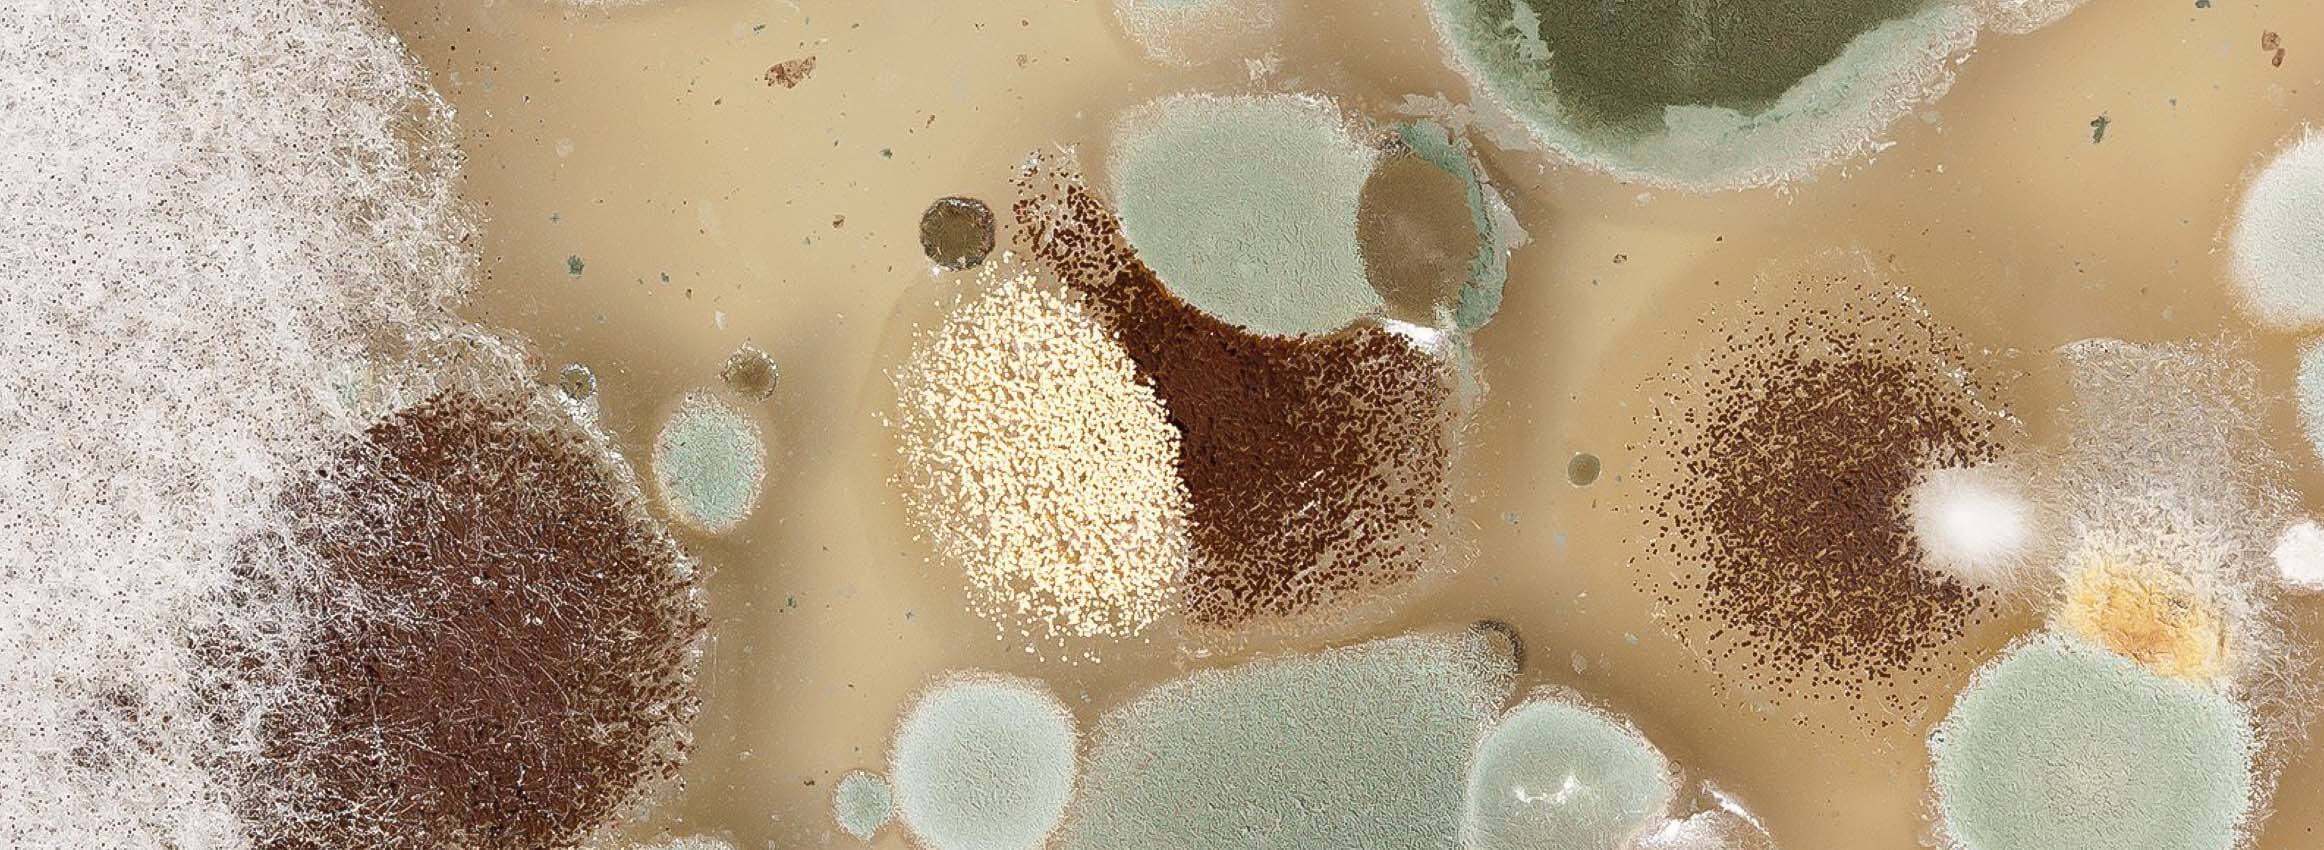
Image

ATKŪRIMAS PO VANDENS UŽLIEJIMO
KAIP ATSIKRATYTI PELĖSIO?
SUSISIEK SU MUMIS!
Ar žinote, kad orbitinių stočių išoriniame paviršiuje, beorėje erdvėje, net prie stipriausio šalčio, formuojasi pelėsis? Žemėje su juo kovoti daug paprasčiau, tačiau be specialių žinių, įrangos ir patirties šio „žvėries“ sunaikinti neįmanoma.
Pelėsį visada sunku pašalinti, o apie jo pavojų žmonių ir gyvūnų sveikatai girdėjo turbūt kiekvienas.
PELĖSIS GALI SUKELTI ŠIAS SVEIKATOS PROBLEMAS
- Alergijas

- Dirgiklius
- Mikotoksinus
- Čiaudulį
- Plaučių ir kvėpavimo problemas
- Ilgalaikes alerginio ir astmatinio pobūdžio ligas
Astma sergantys pacientai gali būti ypač jautrūs pelėsiui. Jei įtariate, kad Jūsų namuose, bute ar biure gali būti pelėsio sporų, kvieskite mūsų specialistus. Mes atliksime matavimus, naudodami specialius prietaisus, tiriančius ar patalpoje yra pelėsio, grybelio, sporų ir mieliagrybių fragmentų.
Jūsų butas ar namas nebūtinai turėjo būti užlietas, pelėsio atsiradimui pakanka po lietaus pratekančio lango.
Netinkamas vandens perteklio pašalinimas ir (arba) netinkamas patalpų ir turto džiovinimas gali būti sudaryti tinkamas sąlygas pelėsio formavimuisi. Jei nekontroliuoti pelėsio, oro kokybė suprastėja ir aplinka tampa nesaugi. Jei kilo problemų dėl pelėsio, kilusio po vandens užliejimo Jūsų namuose, biure, gamybos pastate ar sandėlyje, drąsiai susisiekite su mūsų sertifikuotais restauravimo specialistais, kurie padės pašalinti šią problemą.
SUMAŽINKITE PELĖSIO POVEIKĮ
Pavojingiausia problema po vandens užliejimo yra pelėsis. Kaip tikriausiai žinote, pelėsis klesti drėgnoje ir šiltoje aplinkoje. Po užliejimo paprastai turi praeiti nuo 24 iki 48 valandų, kol pelėsis pradeda sparčiai augti ir plisti po visas patalpas. Gresia pavojus ne tik namui ar kitoms patalpoms, bet ir Jūsų turtui. Bet koks turtas veikiamas drėgmės ilgiau nei dieną, jau gali būti paveiktas pelėsio ar grybelio.
Laimei, mes žinome metodus, kaip galima kontroliuoti ir sustabdyti pelėsio augimą.
Yra daugybė pelėsio rūšių, o kai kurie yra itin toksiški. Štai kodėl jums reikia profesionalių pelėsio šalinimo paslaugų.
AMI Stilius restauravimas ir atkūrimas padės išspręsti pelėsio problemas ir prailgins Jūsų turto tarnavimo laiką. Mes naudojame profesionalią įrangą ir saugiai bei efektyviai pašaliname bet kokį pelėsį, jo sporas ir grybelius.
Pelėsio žalos mažinimas
Namuose, kurie buvo užlieti vandeniu, pelėsio atsiradimui pakanka nuo 24 iki 48 valandų. Todėl nenorint papildomų išlaidų kovojant su šia problema ypač svarbu kuo greičiau pašalinti ne tik vandens perteklių, bet ir drėgmę nuo visko, įskaitant kilimus ir patalynes.
 Daiktą, kurio paviršius yra akytas arba audinys, kuris buvo veikiamas drėgmės daugiau nei 48 valandas, jei jis neturi jokios ypatingos vertės, geriau išmesti.
Daiktą, kurio paviršius yra akytas arba audinys, kuris buvo veikiamas drėgmės daugiau nei 48 valandas, jei jis neturi jokios ypatingos vertės, geriau išmesti.
AR GALIME KONTROLIUOTI PELĖSIO AUGIMĄ PO VANDENS UŽLIEJIMO?
Naudojant teisingą valymo metodiką, galima kontroliuoti pelėsio augimą ant tam tikrų paviršių.
Pelėsiui naikinti naudojame modernius įrankius ir įrangą
Norėdami patikrinti, ar Jūsų namuose ar biure nėra pelėsio, o Jūsų šeima ir darbuotojai yra saugūs, mūsų pelėsio šalinimo ekspertų komanda naudoja tik pačius pažangiausius įrankius ir įrangą.
Tarp mūsų naudojamų įrenginių yra:
- Tikrinimo prietaisai. Pelėsis gali lengvai pasislėpti sunkiai prieinamose vietose, kur galite ne iš karto jį pamatyti. Mūsų specialistai visada naudoja tik specializuotus kontrolės prietaisus, kurie užtikrina, jog pelėsio sporų patalpoje neliks.
- Termo-higrometras. Šis efektyvus prietaisas rodo temperatūros ir santykinės drėgmės rodmenis.
- Drėgmės jutikliai ir drėgmės matuokliai. Drėgmė gali sukelti pelėsio augimą net ir be realios vandens žalos. Mūsų jutikliai ir drėgmės matuokliai padeda mums rasti vietas kur yra padidėjusi drėgmė, taip galime surasti naujai atsiradusias sporas.
Norėdami papildomai taisyklingai išvalyti paviršius ir užkirsti kelią pelėsio plitimui, mes naudojame ploviklius, kurių sudėtyje nėra amoniako arba valiklius, kurių pagrindą sudaro pušų aliejus, vėliau viską dezinfekuojame 10% baliklio tirpalu.
Visada išbandome šią valymo priemonę nedideliame valomo daikto ar paviršiaus plote, kad įsitikintumėme, jog jis nesukels dėmių ar išblukimo.
DĖMESIO: Jei norite atlikti dezinfekavimą savarankiškai, niekada nemaišykite amoniako ir baliklių, susidarę garai gali būti labai toksiški.
KODĖL PIGIAU SAMDYTI PROFESIONALĄ PELĖSIO PAŠALINIMUI?
Pelėsio pašalinimui geriau kviestis specialistą, turintį patirties šioje srityje, sugebantį blaiviai įvertinti žalos dydį ir restauravimo darbų galimybes, susijusias su pelėsio pašalinimu.
Jei norite pakviesti tinkamą įmonę, vandens padarytos žalos pašalinimui ir užkirsti kelią tolimesniam pelėsio augimui, ieškokite tų, kurie turi valymo ir restauravimo sertifikatus, pavyzdžiui, mūsų įmonę “AMI Stilius”. Priešingu atveju galite patirti papildomų išlaidų ir rizikuojate savo sveikata.
PATIKRA IR PELĖSIO PAŠALINIMAS
Bet koks susikaupęs vanduo po linoleumu, parketu ar kituose plyšiuose sukuria palankią aplinką grybeliui, todėl būtina kiek įmanoma sumažinti drėgmę, taip bus išvengta tolimesnių nemalonių padarinių. Mūsų specialistai naudoja specialius ploviklius vietos sterilizavimui ir pelėsio šalinimui. Norėdami pašalinti visus ore esančius teršalus ir nemalonius kvapus mes naudojame dezodoravimą ir vėdinimą.
Mūsų ekspertai kruopščiai išmokyti pažangiausių pelėsio šalinimo būdų.
Jų mokymai apėmė:
- saugumas darbo metu,
- technines kontrolės priemones prieš grybelio ir pelėsio veisimąsi,
- pelėsio ir grybelio suradimo metodus
- kaip naudotis standartizuotais darbo metodais.
Kai jūs samdote AMI Stilius savo poreikiams, jūs samdote kokybę, skaidrumą ir efektyvumą už teisingą kainą.
KOVA SU PELĖSIU GYVENAMUOSIUOSE NAMUOSE

Pelėsis ar grybelis, aptinkamas namuose, biuruose ir darbo vietose, gali sukelti sunkias kvėpavimo takų ligas, todėl neturėtumėte rizikuoti savo sveikata.
Susisiekite su mumis, jei radote net mažiausią pelėsį ar pelėsio pėdsaką savo patalpose - mansardoje, rūsyje ar kitur. Mes teikiame neatidėliotinas pelėsio šalinimo paslaugas pastatų, patalpų savininkams ir nuomininkams.
Mūsų pelėsio naikinimo specialistai naudoja pažangiausias technologijas ir įrangą, kuri garantuotai išgelbės Jūsų patalpas nuo šios problemos. Mūsų specialistai žino, kur ieškoti. Pirmiausia jie patikrina, kas yra paslėpta po pakabinamomis lubomis, nišose, palėpėse, rūsiuose ir už gipso sienų, kad susektų, sustabdytų ir sunaikintų šį priešą visam laikui.
KOVA SU PELĖSIU VERSLO PATALPOSE
Kaip verslo savininkas, Jūs tikrai galvojate apie savo darbuotojus, klientus ir savo sveikatą. Jeigu biure ar pramoninėse patalpose atsirado pelėsio, pavojus kyla visiems.
PSO komunikacijos pareigūnas Fadela Chaib atstovaujantis Pasaulio sveikatos organizaciją viename pranešime teigė, kad atlikęs tyrimus dėl pelėsio pavojaus gyvenamosiose, gamybinėse patalpose ir kitose vietose, priėjo išvados, kad ore esant pelėsiui, grybelių sporoms, ypač micelinių hifų fragmentams, gali grėsti darbuotojų produktyvumo sumažėjimas per pusę. Ilgalaikis buvimas tokiose patalpose sukelia sunkias plaučių ligas, kurios turės būti gydomos ambulatoriškai, ilgą laiką ir ne visada sėkmingai.
Taigi iš pirmo žvilgsnio nekenksmingas pilkumas kampe ar net po tapetais, gali sutrukdyti jūsų sėkmingam verslui.
AMI Stilius siekia išgelbėti Jūsų verslą nuo kiekvieno pelėsio požymio.
Leiskite „AMI Stilius” suteikti Jums profesionalias pelėsio valymo ir šalinimo paslaugas!
Mūsų sertifikuotų valymo ir restauravimo specialistų komanda gali išspręsti net senas problemas geriausiu būdu. Be žinių ir praktinės patirties, mes naudojame moderniausią įrangą, technologijas ir chemines medžiagas, nekenksmingas sveikatai, kurios 100% apsaugo nuo pelėsio ir grybelio susidarymo bei vystymosi.
Kilus įtarimui dėl pelėsio ir grybelio atsiradimo, nedvejodami skambinkite mums telefonu +370 64 688 490 ir gaukite pirmąją nemokamą konsultaciją.
Mielai padėsime kiekvienam, nes esame švaros gerbėjai ir savo srities specialistai.













